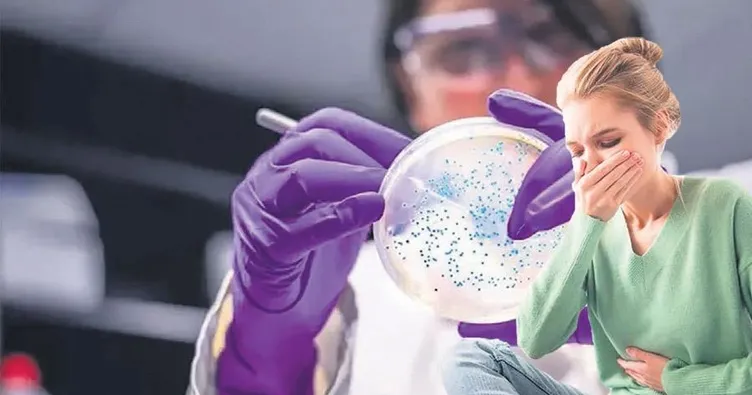

Salmonella bakterisi az pişmiş tavuk etlerinin tüketilmesi ile ortaya çıkan salgınlara yol açabilen bir bakteri. Özel bir üniversitenin Tıbbi Mikrobiyoloji Anabilim Dalı Başkanı Doç. Dr. Özge Ünlü, son günlerde gündemde olan gıda zehirlenmeleri ve Salmonella bakterisine ilişkin önemli bilgiler paylaştı.
PEK ÇOK ENFEKSİYONA YOL AÇAR
Salmonella'nın hem insanlar hem de hayvanlarda enfeksiyon oluşturabilen bakteriler olduğunu belirten Doç. Dr. Ünlü, "Salmonella bakterisi, insanlara sıklıkla, hasta kişiler veya hayvanlarla temas veya bunların dışkıları ile kontamine olmuş su veya gıdaların tüketilmesi ile bulaşır. Sıklıkla besin zehirlenmesi etkeni olarak karşımıza çıkan Salmonella, aynı zamanda tifo, paratifo gibi sistemik enfeksiyonlara da neden olabilir" dedi.

8 İLA 72 SAATTE ORTAYA ÇIKAR
Basit besin zehirlenmelerinin bile 65 yaşından büyük, 5 yaşından küçük veya altta yatan hastalığı olan, bağışıklığı zayıflamış bireylerde ciddi sonuçlar doğurabileceği uyarısında bulunan Doç. Dr. Ünlü, "Bu nedenle şüpheli bir gıda tüketiminden sonra ilk 8 ile 72 saat içerisinde gelişen karın ağrısı, bulantı, kusma, ishal ve bazen de ateş gibi bulgular gösteren kişi, bu bulguları göz ardı etmemeli ve en yakın sağlık kuruluşuna başvurmalıdır" dedi.

AZ PİŞEN TAVUK ETİNE DİKKAT!
Salmonella bakterisinin az pişmiş tavuk etlerinin tüketilmesi ile ortaya çıkan salgınlara yol açtığını belirten Doç. Dr. Ünlü, "Bununla birlikte araştırmalar Salmonella bakterisinin, hem kırmızı hem beyaz etleri kontamine edebildiğini ortaya koymuştur. Bunun yanı sıra Salmonella bakterisinin tavuk yumurtaları, bu kontamine çiğ yumurtalardan hazırlanan mayonez gibi soslar, birçok meyve ve sebzeyi hatta uygun şekilde depolanmayan kuruyemişleri bile kontamine edebildiğini göstermiştir. Bu durum, gıda güvenliğinin önemini ortaya koymaktadır" dedi.

EL HİJYENİ ÇOK ÖNEMLİ
SALMONELLA enfeksiyonlarından korunmada hijyenik önlemlerin de mutlaka alınması gerektiğini vurgulayan Doç. Dr. Ünlü, "Gıdaya temas etmeden önce eller sabunlu su ile en az 20 saniye yıkanmalı. Hasta bir kişinin, teması ile bakteri kişinin eline bulaşabilir ve bu kontamine el ile birinin elini sıkması ile ve ikinci kişinin elini ağzına götürmesi ile de bir bulaş zinciri olasıdır. Bu şekilde bir bulaş daha nadir görülür ama yeri gelmişken enfeksiyon zincirini kırmada el hijyeninin önemini bir daha vurgulamak isterim" dedi.
GÜVENİLİR YERDEN TEMİN EDİN
SALMONELLA enfeksiyonlarından korunmak için alınabilecek önlemlere dikkat çeken Doç. Dr. Ünlü, "Özellikle et ve sebzeler güvenilen market, manav veya kasaplardan temin edilmelidir. Gıdalar tüketilmeden önce iyice pişirilmelidir. Meyveler gibi çiğ tüketilen gıdalar ise iyice yıkandıktan sonra tüketilmelidir" tavsiyesinde bulundu.
